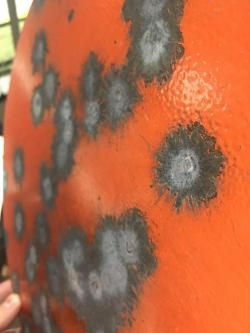
Гонги для стрельбы( бронесталь)

Гонги для стрельбы( бронесталь)
Показать телефон
+7 (916) 519-XX-XX
Автор подтвердил, что изделие продаётся в полном соответствии с федеральным законом 'Об Оружии'. Если у вас есть сомнения, или автором предоставлена недостоверная информация - воспользуйтесь кнопкой 'Пожаловаться'.
Охотничье оружие и ОООП продаётся только при наличии лицензии, с обязательной перерегистрацией в органах Росгвардии.
К сожалению, никто не застрахован от встречи с мошенником. Пожалуйста, ознакомьтесь с данной статьей и будьте бдительны.
Если Вы столкнулись с мошенничеством на нашем сайте, напишите нам и обратитесь в правоохранительные органы. Мы предоставим необходимые данные по официальному запросу.
Сумка санитарная брезентовая без укладки.
2 000 руб. МоскваПредложу в продажу: Сумка санитарная брезентовая без укладки. Производство СССР. С хранения,т.е. пролежавшее вещи несколько лет начиная со времен СССР.могут иметь следы хранения, в виде пятен, изменени...
Костюм зимний NORTH COAST
45 000 руб. Москва, ЗеленоградГОТОВЬТЕ САНИ И ЗИМНЮЮ ЭКИПИРОВКУ ДЛЯ ОХОТЫ, РЫБАЛКИ, СНЕГОХОД ИНГА И ПРОЧИХ ЗИМНИХ АКТИВНОСТЕЙ ЛЕТОМ. ИБО, ЗИМА УЖЕ СКОРО🙂 Зимний, под холодную зиму одежда. Для засидок, зимней рыбалки, для езды на с...
Магазин марадер 4,5/11 и пули люман
1 500 руб. Москва, ИжевскМагазин марадер 4,5 на 11 пуль новый, не использовался. Пули люман 0,55 гр полная пачка продам вместе, отправка да
NRA FUD утки
3 500 руб. МоскваНовые в коробках оригинальные не использованные комплекты уток от NRA FUD: - «NRA FUD Green Wing Teal (Чирок)» 1 (один) комплект (в одном комплекте 6 штук чучел и прочие принадлежности к ним «рем.компле...
Тактическая куртка, демисезонная, мужская, HUSKY.
20 000 руб. МоскваПродаётся куртка в ИДЕАЛЬНЕЙШЕМ состоянии, имела место только примерка при покупке и разовое ношение для определения соответствия интересам и задачам. Приобреталась за цену и в дату обозначенные на одно...
ЛШЗ 2ДТ
20 000 руб. МоскваБоевой шлем ЛШЗ 2-ДТ Размер 1 Комплект: - шлем с визором - чехлы (чёрный, олива, зимний) - переговорное устройство с микрофоном - защита визора для транспортировки - сумка для транспортировки Ле...
Антавка для ружъя
250 руб. Москва, г ЛюберцыАнтабка для ружъя
Крышка ствольной коробки для АК, Сайга
1 200 руб. МоскваКрышка ствольной коробки для АК, Сайги
ПАТРОНТАШ 2 ВИДА Резерва ( RISERVA)
13 000 руб. МоскваНОВЫЕ ДВЕ ПОЗИЦИИ 1 - С ДВУМЯ ПОДСУМКАМИ ДЛЯ НАРЕЗНОГО ОРУЖИЯ - 13000 , ВТОРОЙ ДЛЯ ГЛАДКОСТВОЛЬНОГО НА 26 ПАТРОНОВ - 9 000 . ВСЕ НОВОЕ НИ РАЗУ НЕ ИСПОЛЬЗОВАЛОСЬ .
Брюки SITKA Stratus Pant (США) Новые
49 000 руб. Москва, Раменское100 % оригинальные брюки SITKA Stratus Pant производство США есть возможность примерки. Размеры L и XL. Звоните, ответим на все интересующие Вас вопросы.

Если Вы считаете, что данное объявление нарушает правила нашего портала, то воспользуйтесь ссылкой "Пожаловаться"